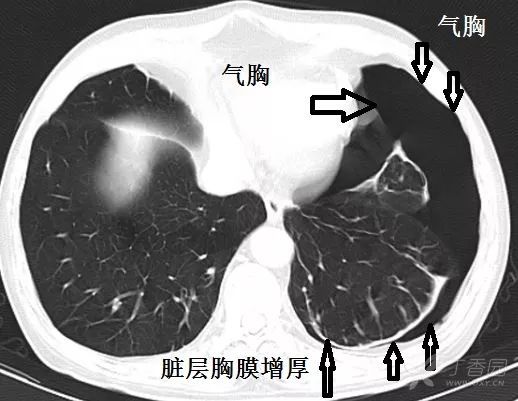
中叶支气管层面,气胸增多.

气管胸段

支气管和肺的分段图
图片尺寸745x745
②气管分为左,右主支气管 气管分为左, 的水平,即气管杈水平; 的水平
图片尺寸1080x810
做好胸科手术麻醉这些支气管解剖知识需掌握
图片尺寸660x850
气道管理10周年从胸外科气道管理变迁看围术期气道管理趋势
图片尺寸513x600
支气管狭窄
图片尺寸1080x810
临床医学五年制局部解剖学课件胸部ppt ③平左主支气管与 食管交叉处
图片尺寸1080x810
气管隆嵴层面
图片尺寸1080x810
解剖丨胸部(胸膜,肺,气管和支气管)~_相关_内容_显示
图片尺寸917x843
胸 气管 主支气管 支气管 腔 主动脉弓 心脏 胸膜腔
图片尺寸1080x810
215.气管和肺段支气管
图片尺寸986x1141
气管胸段
图片尺寸340x418
支气管以下的食管位于后纵隔最前部,食管胸段以
图片尺寸640x911
呼吸与胸部疾病讨论版 帖子详情 嵴角指有中叶支气管与下叶支气管的
图片尺寸1384x716
肺部|气管|肺叶|右肺|胸部
图片尺寸641x801
高清彩图肺支气管的彩色解剖图谱
图片尺寸640x354
支气管以下的食管位于后纵隔最前部,食管胸段以
图片尺寸640x514
气管树,心肺血管空间结构关系,斜裂水平裂的走行之后,我们一起学习
图片尺寸660x473
good 气管解剖 气管是个圆柱形管腔,位于第六颈椎至第五胸椎之间
图片尺寸1080x810
每个叶又分成各个支气管肺段
图片尺寸626x347
中叶支气管层面,气胸增多.
图片尺寸518x401